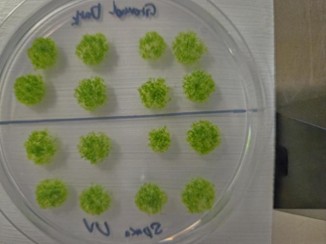

Các nhà nghiên cứu Nhật Bản đã phơi bào tử rêu trong môi trường khắc nghiệt của không gian bên ngoài Trạm Vũ trụ Quốc tế (ISS) trong suốt chín tháng, và kết quả khiến họ bất ngờ khi loại rêu này vẫn sống sót, theo một nghiên cứu mới.
“Đa số sinh vật sống, bao gồm cả con người, không thể sống sót dù chỉ trong thời gian ngắn trong môi trường chân không của không gian,” tác giả chính Tomomichi Fujita thuộc Đại học Hokkaido (Nhật Bản) cho biết. “Tuy nhiên, bào tử rêu vẫn giữ được sức sống sau chín tháng phơi nhiễm trực tiếp. Điều này cho thấy bằng chứng rõ ràng rằng sự sống tiến hóa trên Trái Đất sở hữu các cơ chế nội tại giúp chịu đựng điều kiện ngoài vũ trụ, ít nhất là ở cấp độ tế bào.”
Rêu là một trong những nhóm thực vật cổ xưa nhất trên Trái Đất, xuất hiện hơn 400 triệu năm trước. Chúng thiếu nhiều đặc điểm của các loài thực vật “tiến hóa hơn,” ví dụ như hệ thống mạch dẫn để vận chuyển nước và dinh dưỡng. Dẫu vậy, nhiều loài rêu lại cực kỳ bền bỉ, có thể sống ở các môi trường khắc nghiệt trên khắp thế giới, từ vùng lãnh nguyên Bắc Cực đến sa mạc Sahara.
Fujita và nhóm của ông muốn biết liệu khả năng chịu đựng đó có vượt ra ngoài Trái Đất hay không. Vì vậy, họ gửi bào tử của một loài rêu đất phổ biến có tên “spreading earthmoss” lên tàu chở hàng Cygnus NG-17 của Northrop Grumman, được phóng lên Trạm Vũ trụ Quốc tế (ISS) vào tháng 3/2022.
Nhóm nghiên cứu chọn bào tử, hay cụ thể hơn là thể bào tử (sporophyte) — cấu trúc sinh sản tạo ra bào tử — sau khi tiến hành nhiều thí nghiệm trên Trái Đất. Những thí nghiệm đó mô phỏng điều kiện không gian: môi trường chân không, vi trọng lực, cường độ bức xạ tử ngoại (UV) cao và biến thiên nhiệt độ lớn.
Họ xác định bức xạ UV là yếu tố gây căng thẳng lớn nhất đối với rêu, và các thể bào tử chịu đựng tốt hơn nhiều so với rêu non hoặc tế bào thân rêu.
Vì vậy, họ gửi các thể bào tử lên ISS. Phi hành gia gắn các mẫu ra bên ngoài trạm, nơi chúng lưu lại 283 ngày, rồi được mang về Trái Đất trên tàu hàng Dragon vào tháng 1/2023. Khi kiểm tra mẫu sau chuyến bay không gian, nhóm nghiên cứu hoàn toàn bất ngờ.
“Chúng tôi dự đoán tỷ lệ sống sót gần như bằng 0, nhưng kết quả lại ngược lại: phần lớn bào tử đều sống sót,” Fujita nói. “Chúng tôi thực sự kinh ngạc trước sức bền phi thường của những tế bào thực vật nhỏ bé này.”
Thực tế, hơn 80% thể bào tử vẫn còn sống, và 89% trong số đó có thể tiếp tục nảy mầm trong phòng thí nghiệm. Không gian gây ra mức giảm 20% lượng chlorophyll a — sắc tố chính của quang hợp — nhưng bào tử vẫn khỏe mạnh.
Theo mô hình toán học mà nhóm phát triển sau thí nghiệm nêu trên, các thể bào tử thậm chí có thể sống sót lâu hơn nhiều — khoảng 5.600 ngày trong môi trường không gian.
“Thí nghiệm này cho thấy sức sống bền bỉ đáng kinh ngạc của sự sống bắt nguồn từ Trái Đất,” Fujita nói. Trước đây, sức bền này cũng đã được ghi nhận ở nhiều sinh vật khác như vi khuẩn.
Nghiên cứu mới còn có thể mang ý nghĩa lớn đối với các hành trình ra ngoài Trái Đất trong tương lai.
“Cuối cùng, chúng tôi hy vọng nghiên cứu này mở ra một hướng mới để xây dựng hệ sinh thái trong các môi trường ngoài Trái Đất như Mặt Trăng hoặc sao Hỏa,” ông nói. “Tôi hy vọng nghiên cứu về rêu sẽ là điểm khởi đầu.”
Nghiên cứu mới được công bố ngày 20/11 trên tạp chí iScience.

Phía trên trung tâm của một thể sinh dưỡng có thể thấy một thể bào tử màu nâu đỏ. Nang này chứa vô số bào tử bên trong. Các thể bào tử trưởng thành như vậy đã được thu thập riêng lẻ và dùng làm mẫu cho thí nghiệm phơi nhiễm không gian trên ISS. Ảnh: Tomomichi Fujita
Bào tử rêu nảy mầm sau khi tiếp xúc môi trường không gian. Ảnh: Tiến sĩ Chang-hyun Maeng và Maika Kobayashi

